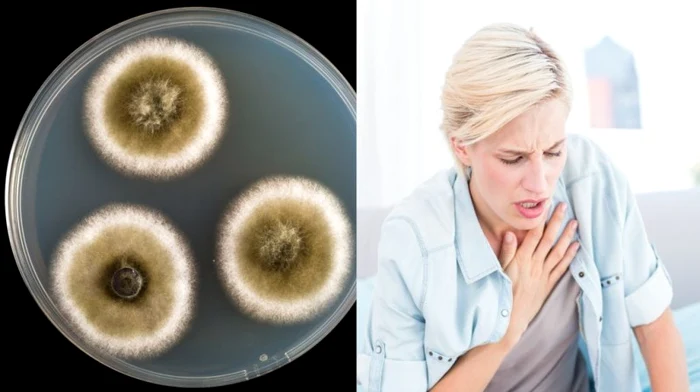
1 15 simptome care iti spun ca esti intoxicata cu mucegai din0 jpg jpeg

Boli din cauza mucegaiului
Mucegaiul din casa nu este doar o problema estetica. Prezenta acestuia iti poate afecta sanatatea intr-un mod serios. Mucegaiul este, de fapt, o ciuperca ce creste in zonele cu umezeala.
Unele mucegaiuri eliberează toxine care afectează sistemul nervos. Ele pot produce dureri de cap, dificultăţi de concentrare şi chiar depresie. Mai mult, în unele cazuri, inhalarea sporilor de mucegai a fost asociată cu oboseala şi cu apariţia problemelor de memorie.
De asemenea, expunerea îndelungată la micotoxinele sintetizate de unele mucegaiuri poate duce la probleme articulare şi musculare, tulburări neurocognitive, probleme de vedere şi boli gastrointestinale şi renale.
Mucegaiurile pot fi, de asemenea, şi o cauză a apariţiei sau agravării astmului. Există o teorie potrivit căreia frecvenţa tot mai mare a acestei afecţiuni respiratorii este consecinţa tendinţei oamenilor de a petrece mult timp în spaţii închise. Totodată, şi sinuzita fungică poate fi o altă consecinţă a inhalării sporilor de mucegai din casă.
Atunci cand apare in locuinta, mucegaiul te poate intoxica pe masura ce ciuperca elimina sport in aer. Acestia ajung in corp, insa intoxicatia este destul de greu de diagnosticat.
Se pot imbolnavi persoane de toate varstele. Sporii pot agrava astumul si iti pot afecta sistemul nervos central. Cele mai comune simptome ale intoxicatiei sunt iritatia in gat, tusea, problemele respiratorii, aparitia sinuzitelor si rinitelor.
In plus, fii atenta la aceste 15 simptome:
1. Probleme cu memoria si lipsa de concentrare.
2. Oboseala si slabiciune.
3. Crampe, dureri articulare.
4. Dureri de corp.
5. Ameteli.
6. Dureri de cap.
7. Vedere in ceata, sensibilitate la lumina.
8. Rinita, sinuzita, tuse, astm.
9. Tremur si vertij.
10. Diaree, schimbari de apetit.
11. Gust metalic in gura.
12. Crestere in greutate.
13. Transpiratii nocturne.
14. Sete excesiva.
15. Urinare frecventa.
























